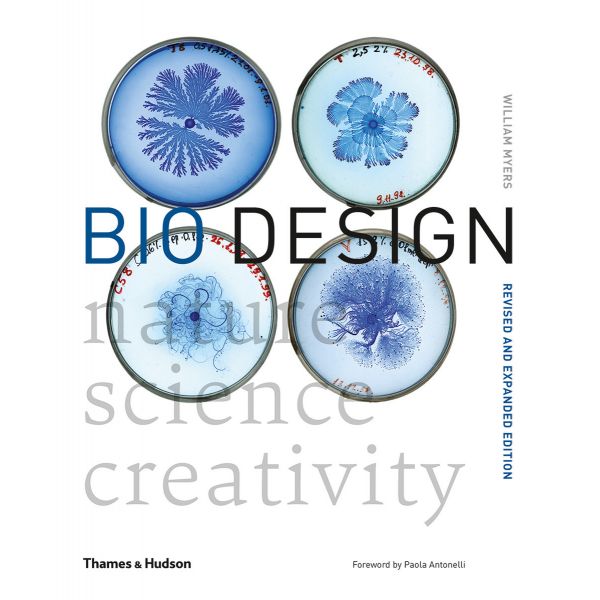
BIO DESIGN: Nature, Science, Creativity

BIO DESIGN: Nature, Science, Creativity
304
мека
английски
2018
29.09.2018 г.
21549439
9780500294390
THE SENSATIONAL NEW PSYCHOLOGICAL THRILLER FROM THE INTERNATIONALLY BESTSELLING AUTHOR OF THE GIRL BEFORE
THE SUNDAY TIMES BESTSELLER
THE SUNDAY TIMES BOOK OF THE MONTH
'Imaginative, unusual, clever and fun' - Sunday Times
'A twisty, exciting read' - Sabine Durrant, author of Lie With Me
'A dark, sexy mystery' - Metro
**********
Claire Wright likes to play other people.
A British drama student, in New York without a green card, Claire takes the only job she can get: working for a firm of divorce lawyers, posing as an easy pick-up in hotel bars to entrap straying husbands.
When one of her targets becomes the subject of a murder investigation, the police ask Claire to use her acting skills to help lure their suspect into a confession. But right from the start, she has doubts about the part she's being asked to play. Is Patrick Fogler really a killer . . . Or the only decent husband she's ever met? And is there more to this set-up than she's being told?
And that's when Claire realises she's playing the deadliest role of her life . . .
**********
See what everyone is saying about JP Delaney, the hottest new name in psychological thrillers:
'DAZZLING' - Lee Child
'ADDICTIVE' - Daily Express
'DEVASTATING' - Daily Mail
'INGENIOUS' - The New York Times
'COMPULSIVE' - Glamour Magazine
'ELEGANT' - Peter James
'SEXY' - Mail on Sunday
'ENTHRALLING' - Woman and Home
'ORIGINAL' - The Times
'RIVETING' - Lisa Gardner
'CREEPY' - Heat
'SATISFYING' - Reader's Digest
'SUPERIOR' - The Bookseller
'MORE THAN A MATCH FOR PAULA HAWKINS' - Sunday Times
Вие оценявате:

Вашите заявки се обработват всеки работен ден от 9,30 до 18,00 ч.
Направени до 16,00 ч. поръчки за страната и чужбина се предават на куриерска служба в рамките на 3 работни дни или според графика за обслужване на съответното населено място.
За страната Книгомания работи само с куриерска служба „Спиди".
Доставките за София на наличните заглавия се изпълняват от куриер на Книгомания в рамките на два работни дни.
Доставката в рамките на страната е 1.99 €
При поръчки на стойност над 25.05 € доставката е безплатна.
Всички цени на Продуктите или Услугите са крайни, обявени са в евро (EUR) с включено ДДС и всички други изисквани данъци или такси, без цена за обработване и доставка, която е посочена отделно, в случай, че такава се дължи.
1 EUR е равно на 1.95583 лева.
Приемат се плащания с наложен платеж, чрез e-Pay и PayPal.